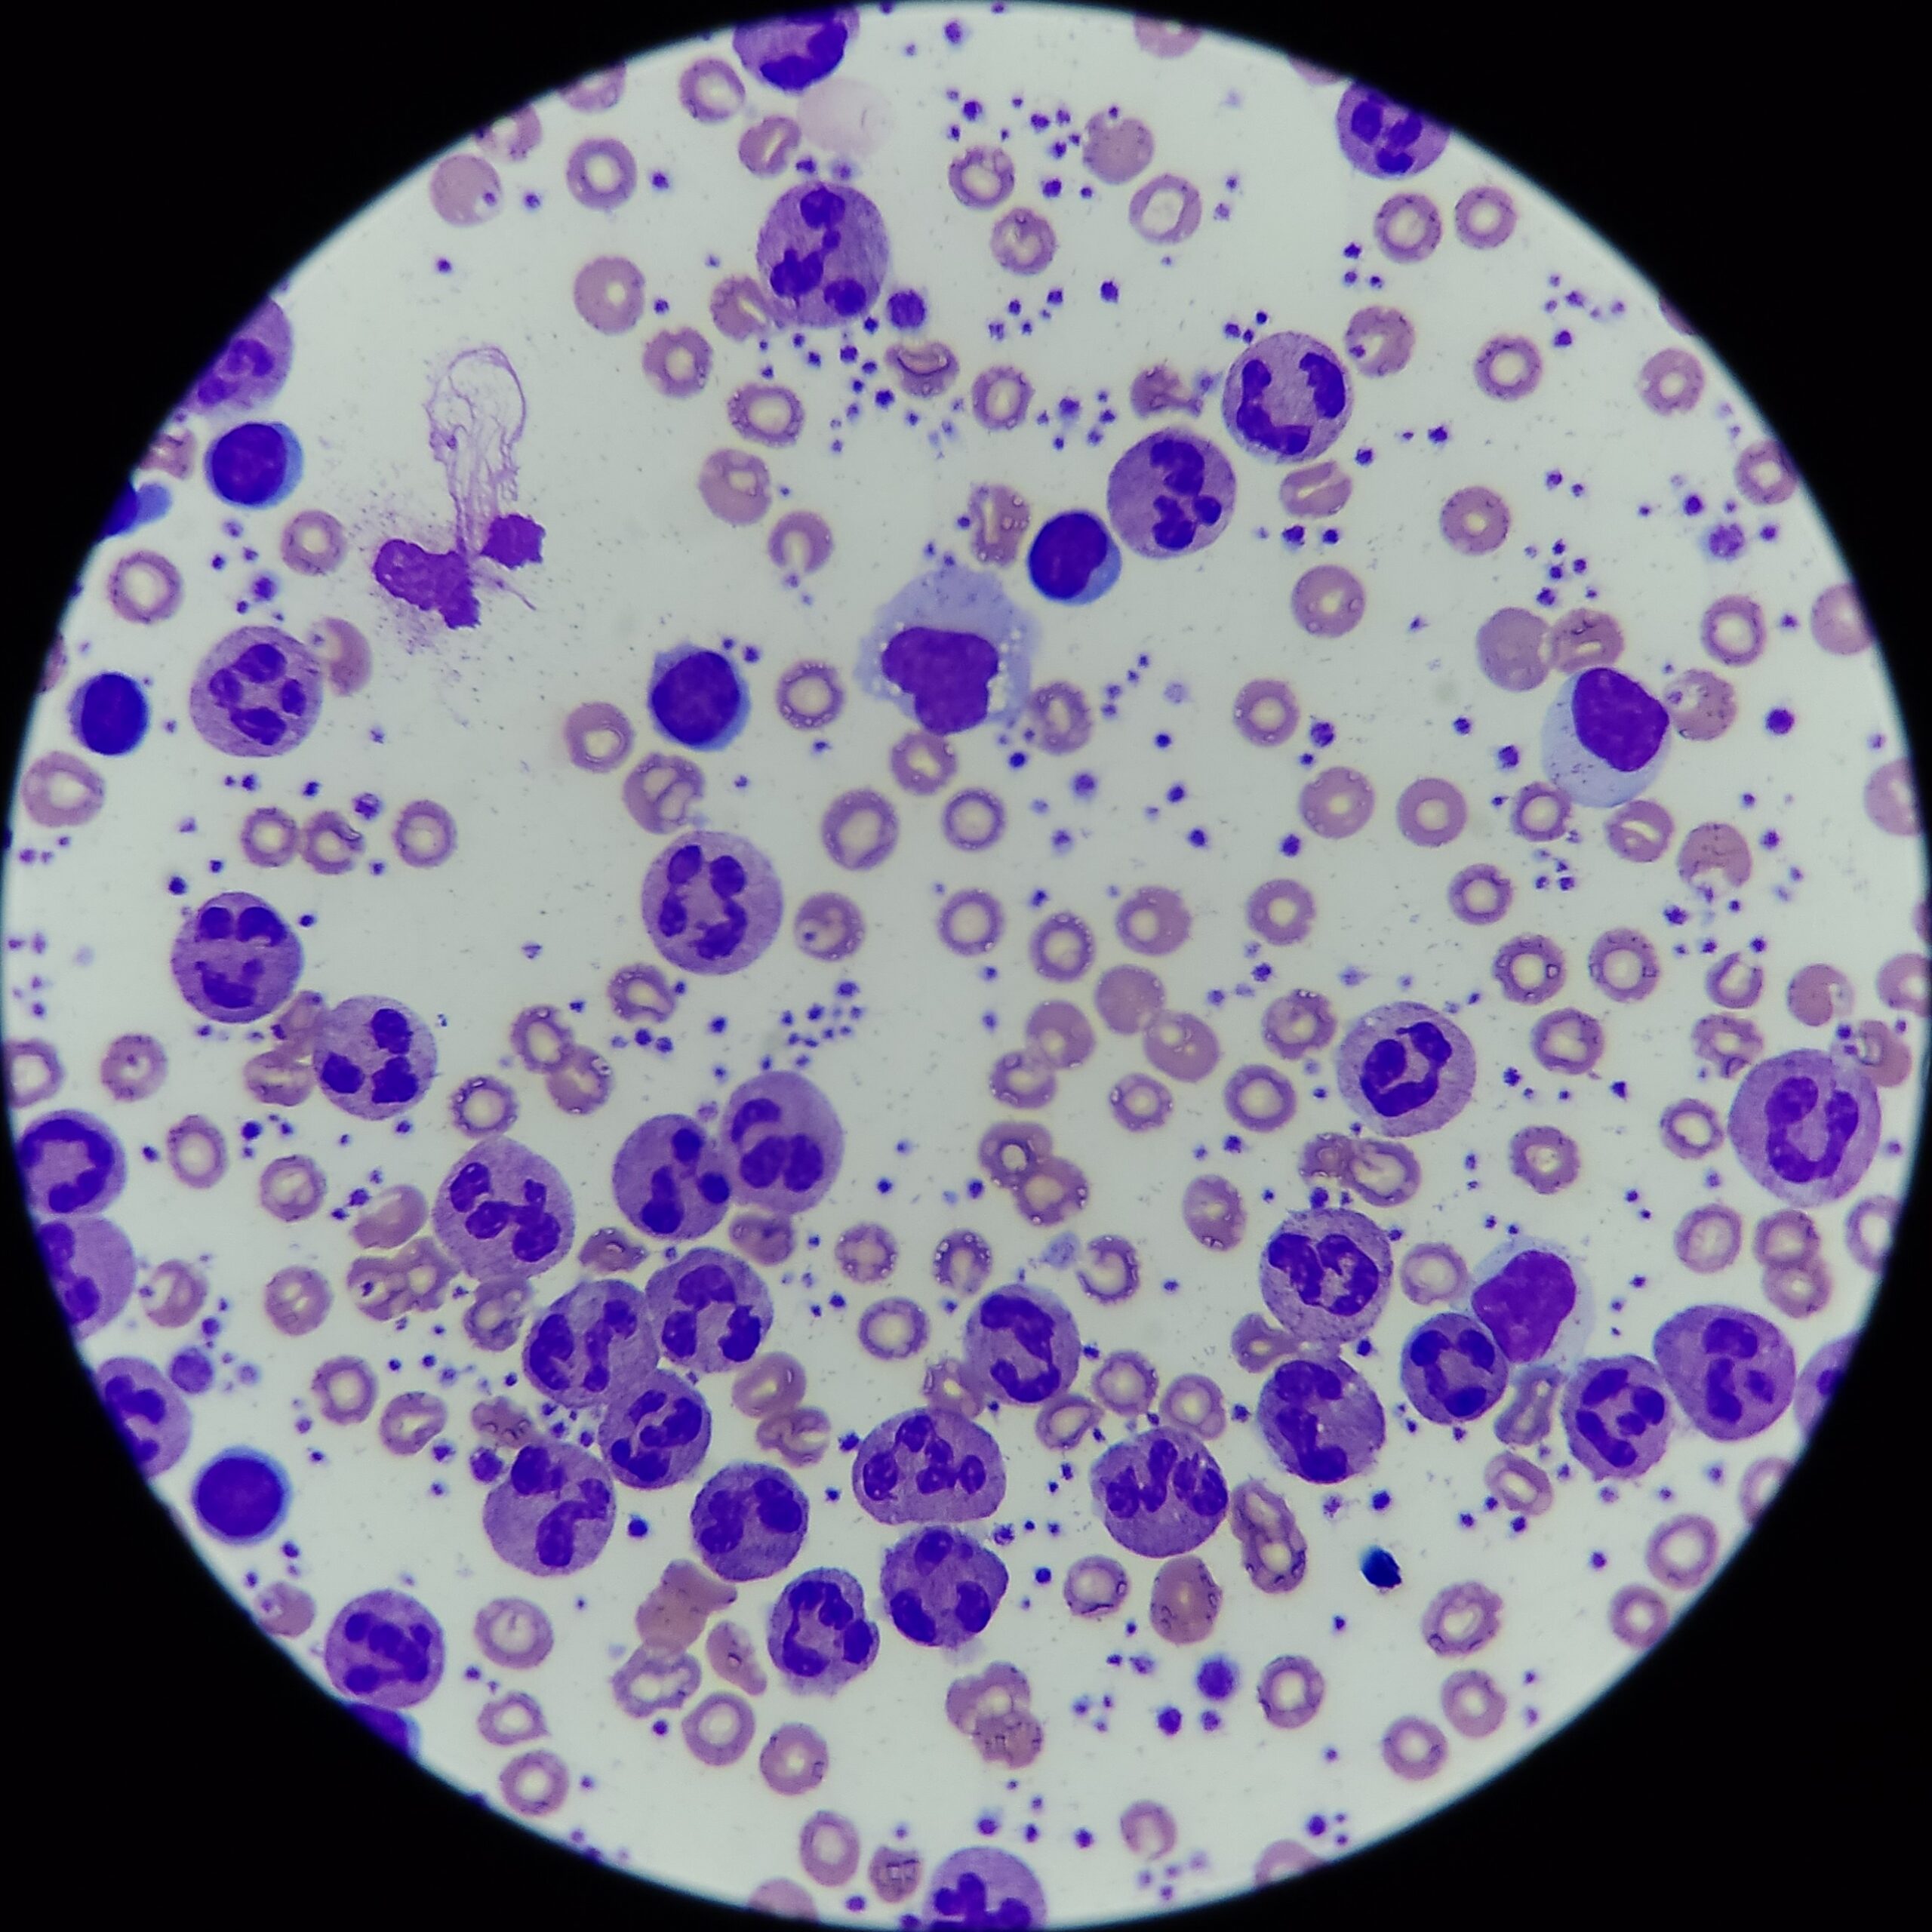
__wf_reserved_inherit

La Cuarta Edición del Concurso Estatal de Fotografía Científica 2024,convocado por el Consejo de Ciencia y Tecnología del Estado de Puebla y la Secretaría de Educación, tuvo a bien promover en la comunidad en general, y en particular en grupos escolares, científicos, culturales y sociales, un acercamiento a la cultura visual de las humanidades, ciencia, tecnología e innovación, a través de la fotografía científica.
Hubo una amplia participación, con recepción de fotos del 15 de febrero al 12 de marzo de 2024, en las tres categorías:
Categoría A. Avanzados y profesionales (mayores de 18 años)
Categoría B. Principiantes (juveniles y mayores de 18 años)
Categoría C. Principiantes (infantiles 8 a 11 años y juveniles hasta los 15 años)
Resultados
En la Categoría A. Avanzados y profesionales (mayores de 18 años) el primer lugar fue para César Maximiliano Vázquez Franco, con la fotografía Monstruo del suelo.

La fotografía muestra la cabeza en vista dorsal de un soldado de hormiga de la especie Pheidole lamia, una hormiga con una morfología cefálica bastante particular, pues presenta una cabeza fragmótica, la fragmosis es una estrategia evolutiva en la que una parte del cuerpo es usado como barrera física para evitar la entrada de intrusos en los nidos o madrigueras, en consecuencia, la cabeza se ve algo chata y tosca en su región anterior. Este tipo de fotografía es usado con fines descriptivos en Sistemática Zoológica, pues permite la ilustración de los caracteres de la cabeza.
La fotografía se obtuvo con una combinación de dos técnicas la primera llamada macro extremo, en la que el objetivo macro convencional de una cámara se sustituye por un objetivo de microscopio, lo que permite lograr fotografías de objetos más pequeños. La segunda técnica se llama stacking o apilado, varias fotografías tomadas a diferentes planos equidistantes se combinan para lograr una foto en foco. Cuando se trabaja con objetos muy pequeños, la distancia focal se reduce o que evita que un objeto pueda ser enfocado por completo, de ahí que el apilado permita recuperar los diversos planos en foco de un conjunto de fotos.
La fotografía final tiene dos tipos de edición adicional, el primero es la remoción con ayuda del pincel corrector puntual de partículas de polvo sobre el ejemplar y artefactos (llamados pixeles quemados), que se forman debido a que usamos un objetivo no desarrollado para este uso; finalmente la última edición es la inserción de una escala que permite dimensionar la hormiga, ya que, en fotografía científica, las escalas son vitales para referencias posteriores.
El segundo lugar lo obtuvo Job Ramírez Solano con la fotografía titulada Partículas de magnetita.

La magnetita es un mineral de hierro con propiedades magnéticas intrínsecas. Cuando el campo magnético sobre los átomos de hierro alcanza una intensidad significativa, las interacciones entre átomos adyacentes dan lugar a la formación de grupos de átomos alineados, creando lo que se conoce como dominios magnéticos. La magnetita, en particular, exhibe este fenómeno de alineación de dominios magnéticos cuando se expone a un campo magnético externo. Por ejemplo, al situarla cerca de un imán de neodimio, un material ferromagnético de alta potencia con un valor superior a 8500 veces el campo magnético terrestre, las partículas de magnetita, con un tamaño aproximado de 200 nanómetros, tienden a alinearse siguiendo las líneas del campo magnético generado por el imán.
Este fenómeno de alineación puede ser observado visualmente a través de la disposición ordenada de las partículas de magnetita en la dirección del campo magnético.
Al retirar la influencia del campo magnético externo, algunas partículas de magnetita pueden retener su alineación magnética, comportándose como pequeños imanes individuales durante un período de tiempo determinado, dependiendo de las características de los materiales y del entorno circundante.
En la Categoría B. Principiantes (juveniles y mayores de 18 años), el primer lugar lo obtuvo José Alberto Sierra Romero con la fotografía Concentrado leucocitario.
En la fotografía adjunta, señala su autor, presento una micrografía de un concentrado leucocitario. La técnica para la obtención de este concentrado la he estado trabajando durante algunas semanas en el laboratorio de análisis clínicos de mi universidad, es difícil acceder a materiales como tubos Wintrobe para obtener de manera más sencilla los leucocitos, por lo que mi proceso para obtener este tipo de muestras es más simple y por tanto se observan algunos eritrocitos en el campo.
Recolecto sangre en un tubo lila y lo centrifugo durante 10 minutos a 1300 RCF, esto me ayudará a separar el plasma de los eritrocitos y tener en la interfase tanto plaquetas como leucocitos, luego de lograr la separación, con ayuda de una micropipeta de 5 uL extraigo con cuidado una porción de la interfase, procurando no extraer demasiados eritrocitos en el proceso y extraer suero suficiente para que el extendido en el portaobjetos sea favorecido dada la presencia de albúmina del suero, luego de colocar la gota de 5 uL sobre un portaobjetos hago un extendido como se hace en los frotis sanguíneos normales, dejo secar 30 minutos y hago una tinción de Wright. Actualmente sigo buscando un método que me dé buenos resultados sin la necesidad de usar tubos Wintrobe, además de que sea fácil y práctico para que lo puedan implementar mis otros compañeros.
La observación de estas laminillas las hago usando aceite de inmersión para el objetivo de 100 aumentos y he logrado conseguir micrografías interesantes que sirven para familiarizarnos con las distintas morfologías de los leucocitos en un solo campo. Luego de verificar que las muestras sean útiles, las monto en resina para que puedan ser ocupadas en el laboratorio en repetidas ocasiones sin dañarse el extendido.
El segundo lugar en esta categoría lo obtuvo María Fernanda Morales L. con Esencia cromática.

El espectro es cuando la luz blanca atraviesa ciertos elementos ópticos, ya sean prismas, redes de difracción o incluso gotas de agua; la luz se desdobla y se descompone en sus colores que la componen.
Cuando el elemento óptico dispersor es suficientemente potente, puede revelar los colores mucho más allá de lo que el ojo es capaz de apreciar. Lo que sucede en realidad es que la luz, es una onda formada por diferentes frecuencias. Los colores azules que vemos tienen frecuencias algo mayores que los colores rojos. Los rayos infrarrojos (que no vemos y, por eso, no podemos propiamente llamarlos colores) tienen frecuencias todavía más pequeñas, y los rayos ultravioletas (que tampoco vemos) las tienen mayores que los colores azules y violetas. Así, descomponer la luz en colores es descomponerla en frecuencias. Llamamos espectro al resultado de separar las frecuencias presentes en la luz, o más precisamente la radiación, y medir la cantidad de energía recibida en cada una de esas frecuencias. Las radiaciones como los rayos ultravioleta (UV), los rayos X y los rayos gamma. Estas clases de radiación son dañinas para los organismos vivos, pues tienen frecuencias
extremadamente altas, esto quiere decir que tiene mucha energía. Es por esta razón que usamos loción bloqueadora en la playa (para bloquear los rayos UV provenientes del sol) y que, para prevenir que los rayos X penetran otras áreas del cuerpo distintas de la que requiere visualizarse, un técnico de rayos X coloca una placa de plomo sobre nosotros. Los rayos gamma son los más dañinos, pues son los más altos en frecuencia y en energía.
Por último, en la Categoría C. Principiantes (infantiles 8 a 11 años y juveniles hasta los 15 años), el primer lugar fue para Ángel Armando López Gaeta con la fotografía Travesía luminosa.

La refracción es el fenómeno por el cual la luz que se propaga en forma de onda cambia de velocidad al pasar de un medio material a otro distinto, por ejemplo, cambiar del aire al agua como lo muestra mi fotografía .La refracción ocurre cuando la luz se dobla al pasar de una sustancia transparente a otra.
Un caso común donde se producen este tipo de fenómenos es cuando vemos un arcoíris. La luz producida por los rayos solares atraviesa las gotas de agua de lluvia que hay en la atmósfera en ángulos distintos esto hace que se produzca la refracción y que la luz blanca que nos llega se descomponga en un conjunto de colores. También en los espejismos son un caso muy extremo de refracción al que se le denomina reflexión total. La onda de luz atraviesa varias capas de aire a distinta temperatura donde los índices de refracción en cada capa son distintos entre sí.
Por ejemplo, la velocidad de la luz en el vacío es de 300.000 km/s, mientras que en el aire es ligeramente inferior (en torno a 299.900 km/s), y en el agua está por debajo de ambas: cerca de 250.000 km/s.
El índice de refracción (n) se calcula al relacionar la velocidad de la luz en el vacío (c) con la velocidad de la luz en el medio (v). Los objetos que funcionan con la refracción de la luz son los lentes, las lupas, las cámaras de video y los telescopios, mientras que otros aparatos funcionan utilizando la reflexión de la luz como los periscopios y caleidoscopios.
El segundo lugar fue para El mundo continuo, fotografía de Diego Flores Martínez.

En su descripción de la imagen señaló: “Hay fotos, imágenes, momentos que no son planeados, solo ocurren y se captan, las percibimos, las concientizamos y quizás olvidamos. Esta foto es una de tantas que tomé durante una exposición de arte inmersivo en el museo Barroco de mi estado, Puebla.
“En la fotografía se muestra una mujer joven viendo quizás un futuro o un pasado, sentada en un tiempo neutral, con un horizonte profundo, que da un toque infinito. Preparada con su bolso y con un aditamento que se incorporó a nuestra vida después de la pandemia.
“Los tiempos en los que ahora me toca vivir, el arte va de la mano con la ciencia echando mano de los medios de innovación digital sumergiéndonos a una experiencia física que genera sensaciones químicas.
“Antes, uno se acercaba a las obras de arte, ahora ellas nos envuelven con sus colores, movimientos, sonidos y olores, nos fusionan con ayuda de la inmersión, activando los sentidos y permitiéndonos ser parte de ellas.
“¿Has sentido en el pecho esa sensación de que te hundes y fluyes con las imágenes? eso es una conexión entre tus sentidos y el arte, que genera la segregación de sustancias dentro de tu cuerpo causándote cambios, ya sea de alegría, nostalgia, tristeza, vacío, angustia, etc.; lo que nos debería hacer pensar en la correlación de la dinámica de los fluidos de las imágenes y su impacto en los cambios de concentraciones de nuestras sustancias celulares al vivir el arte. El experimentar la inmersión impacta nuestros sistemas anatómicos, especialmente el nervioso, ya que activa nuestras neuronas influyendo nuestro estado de bienestar, en pocas palabras, algo que ahora es estudiado como Neuroestética.
“Darse un tiempo para vivir, entender y sentir el arte es experimentar otra forma de nutrición para el cuerpo y el alma.
El tercer lugar fue para Jetzamin Andrea Castillo Mendoza, con la fotografía El parásito que invade el cerebro humano.

La descripción de la obra señala: Las babosas o limacos son moluscos de tierra, sin concha, de tamaño variable: puede medir entre 1 y 15 cm de longitud. Durante las noches o días nublados salen a la superficie. Se desplaza gracias al líquido que segrega su cuerpo y le permite arrastrarse fácilmente. Suelen vivir de 8 a 18 meses según la especie y lugar. En las regiones de las costas atlántica y pacífica son propicias para los caracoles y babosas siendo las más afectadas.
Las autoridades de salud han advertido a la gente de que no los toquen, sin tener las manos protegidas, ya que pueden contener el parásito infeccioso. Los científicos creen que esta repentina difusión se debe al cambio climático y la globalización, que extiende los parásitos por todo el mundo. Las babosas son las responsables de contagiar a los humanos de una rara infección parasitaria que recibe el nombre de ”Angiostrongylus” y que puede causar graves problemas de salud e incluso causar la muerte.
La angiostrongiliasis comienza con una infección de los pulmones, la sangre y en el cerebro, transmitida por estos animales. Los humanos se contagian al ingerir alguno de estos pequeños animales provocando en las personas enfermedades como la meningitis. La enfermedad suele provocar temblores, dolor o inflamación del cerebro y que a menudo puede causar la muerte.
“Un paso clave para evitar la infección de angiostrongiliasis consiste en eliminar los caracoles y las babosas del hogar y el jardín, la limpieza de estos es vital ya que se previene los espacios de refugios de estos animales. Cuando ingieras alimentos como frutas o verduras asegúrate de desinfectarlos y lavarlos bien, y sobre todo no elijas este delicioso manjar como platillo exótico.”



